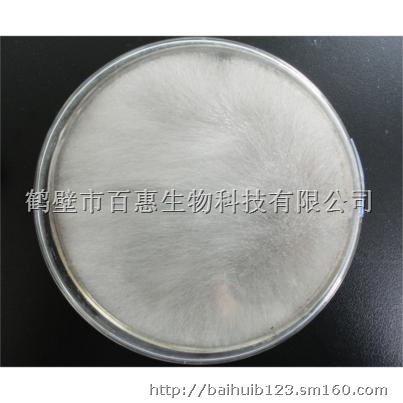

商品详情

毛霉
请选择 型号/数量
商品详情
大量供应BM毛霉菌种
本品为接合菌亚门、接合菌纲、毛霉目、毛霉科、毛霉属(Mucor)的腐生真菌,异养需氧型,以孢囊孢子和接合孢子繁殖。菌丝无隔、多核、分枝状,在基物内外能广泛蔓延,无假根或匍匐菌丝。不产生定形淡黄色菌落。菌丝体上直接生出单生、总状分枝或假轴状分枝的孢囊梗。各分枝顶端着生球形孢子囊,内有形状各异的囊轴,但无囊托。囊内产大量球形、椭圆形、壁薄、光滑的孢囊孢子。孢子成熟后孢子囊即破裂并释放孢子。有性生殖借异宗配合或同宗配合,形成一个接合孢子。某些种产生厚垣孢子。毛霉菌丝初期白色,后灰白色至黑色,这说明孢子囊大量成熟。
毛霉在中温、高湿以及通风不良的条件下生长良好。能糖化淀粉并能生成少量乙醇,蛋白酶活力强。许多毛霉能产生草酸、乳酸、琥珀酸及甘油等,有的毛霉能产生脂肪酶、果胶酶、凝乳酶等。
BM毛霉菌种的用途:(1)由于本品有分解大豆蛋白的能力,故常用于制作毛豆腐、毛豆渣、腐乳和豆豉等豆制品。(2)由于本品能产生淀粉酶,可以用于制曲和酿酒。(3)在有机肥发酵生产中,毛霉可以分解原料中的纤维素、半纤维素、粗蛋白等难分解物质,促进原料转化为作为可以吸收利用的物质,并产生 “白毛”。经毛霉发酵的原料施入土壤后,在条件适宜的情况下,可以在土壤中生长繁殖,加速养分的转化,促进作物对养分的吸收,有效地解决土壤板结、有害菌群滋生、有机质减少、土壤营养失衡等问题。
本品安全可靠,无毒副作用,请放心使用。